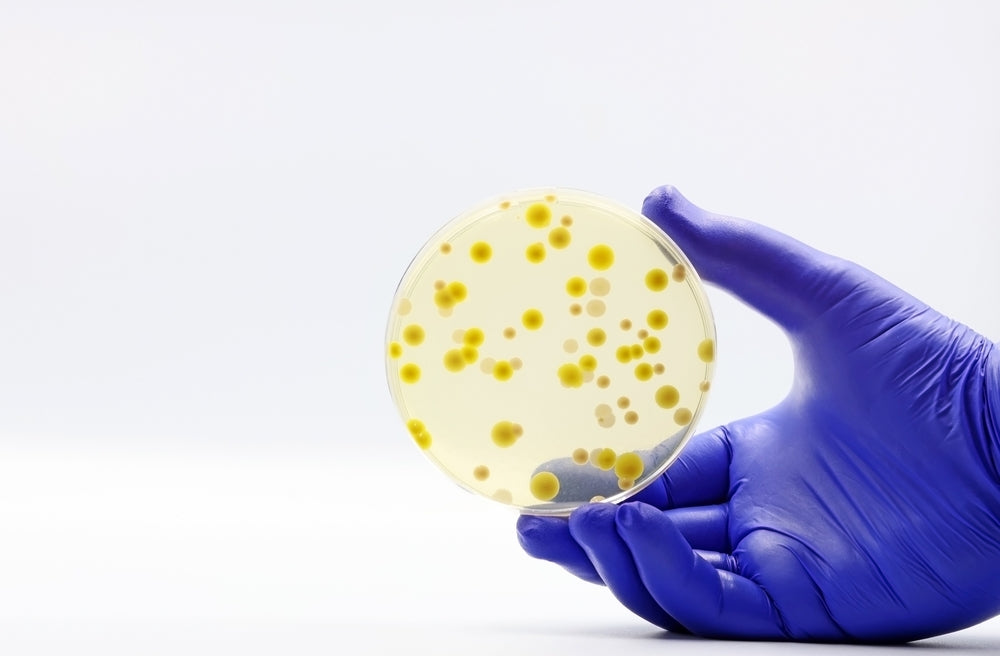
What Is the Gut Microbiome and Why It Shapes So Much of Your Health

What Is the Gut Microbiome and Why It Matters
You’ve probably heard the term gut microbiome before. It’s more than a buzzword — it’s the invisible ecosystem that affects how you digest, feel, think, and even how your immune system responds.
At beie., the microbiome is at the heart of everything we do. So let’s take a moment to understand what it actually is, and why caring for it is one of the best things you can do for your health.
Microbiota vs. Microbiome — What’s the Difference?
When reading about gut health, you might see two similar words: microbiota and microbiome.
Here’s the simple difference:
- Microbiota = the living microorganisms in your body (bacteria, yeasts, viruses, fungi…).
- Microbiome = all the genes of those microorganisms — essentially, their entire biological “blueprint.”
In everyday language, we usually just say microbiome, especially when talking about the gut.
Why the Gut Microbiome Matters
The gut microbiome is made up of trillions of microorganisms that live mainly in your intestines.
Each of us has a unique microbial “fingerprint,” and these microbes are constantly working — digesting food, training your immune system, and producing important compounds that influence your whole body.
The gut and the immune system are deeply connected. A balanced microbiome helps regulate immune responses and supports white blood cell activity, even in the brain.
And when people say “immunity starts in the gut,” — they’re absolutely right.
But that’s not all.
Up to 80 % of serotonin — the hormone of happiness — is produced in your gut.
Your microbiome also produces dopamine, which affects motivation, satisfaction, and cravings.
In short: a happy gut really does mean a happier you.
How the Gut “Talks” to the Rest of the Body
The microbiome doesn’t work in isolation — it communicates.
Your gut microbiome constantly interacts with your skin microbiome, your immune system, and even your brain.
You’ve probably felt this connection yourself:
- Stress giving you stomach cramps.
- Butterflies in your belly when you’re in love.
- A gut feeling that turned out to be right.
Science now calls this the gut–brain axis — a real, two-way communication system between your digestive tract and your nervous system.
Can We Influence It?
If our microbiome plays such a powerful role, what happens when it’s out of balance — and can we fix it?
That’s the question scientists are exploring right now. Research into the microbiome is still young, but it’s growing fast. Every new study reveals how much potential this microscopic world holds for improving digestion, immunity, mental health, and more.
How to Support and Rebalance Your Gut Microbiome
The good news is that you can nurture and even reshape your microbiome — starting today.
The most natural way is through probiotics — live microorganisms that benefit your gut when consumed in the right amounts.
They occur naturally in fermented foods like yogurt, kefir, sauerkraut, and kimchi. But to target specific needs, you can also choose scientifically designed probiotic supplements.
Each probiotic strain has its own strengths — some support digestion, others immunity, others mood or metabolism.
So if you want to restore balance, the key is finding the right combination — like completing a puzzle made just for your body.
💛 Discover b.harmony
— a blend of clinically studied probiotic strains that help your microbiome stay balanced and resilient.
🌿 Explore b.align
— a targeted prebiotic flaviobiotic designed to support your gut barrier, enhance beneficial butyrate-producing bacteria and strengthen overall gut–microbiome health.
The Microbiome: A Universe Within You
Your gut microbiome is not just a part of you — it is you.
It influences your energy, your immunity, your emotions, and your overall wellbeing.
When you take care of it, it takes care of you.
beie. — because harmony starts within.